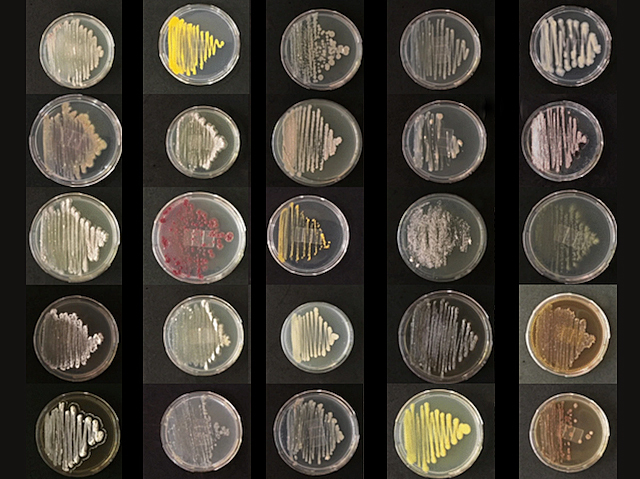

Antarctic microbes as a source for new cancer drugs
03 September 2020
Drugs on Ice
As well as causing unpleasant infections that make us sick, bacteria can also help to make us well again. Several species of bacteria produce chemicals that have been turned into drugs such as antibiotics and cancer treatments. This has led to an activity known as bioprospecting – scouring the natural world in search of new bacterial species that might produce potent novel drugs for all kinds of conditions. The more unusual the conditions, the stranger the bacteria that live there and the more interesting the molecules that they produce. There are few places on earth as strange as Antarctica, with its extreme cold, high saltiness and lack of human interference. These plates contain colonies of Actinobacteria isolated from Antarctic hair grass – one of only two flowering plants native to the frozen continent. Some of them make molecules that could be promising cancer drugs, which can be taken forward for testing.
Written by
- Image adapted from work by Leonardo Jose Silva and colleagues
- Laboratory of Environmental Microbiology, Brazilian Agricultural Research Corporation (EMBRAPA) – Embrapa Environment, Jaguariúna, SP, Brazil
- Image originally published under a Creative Commons Licence (BY 4.0)
- Published in Scientific Reports, August 2020
Search The Archive
Submit An Image
Like us on Facebook
Follow on Twitter
Follow on Tumblr
Follow on Instagram
What is BPoD?
BPoD stands for Biomedical Picture of the Day. Managed by the MRC Laboratory of Medical Sciences until Jul 2023, it is now run independently by a dedicated team of scientists and writers. The website aims to engage everyone, young and old, in the wonders of biology, and its influence on medicine. The ever-growing archive of more than 4000 research images documents over a decade of progress. Explore the collection and see what you discover. Images are kindly provided for inclusion on this website through the generosity of scientists across the globe.
BPoD is also available in Catalan at www.bpod.cat with translations by the University of Valencia.








